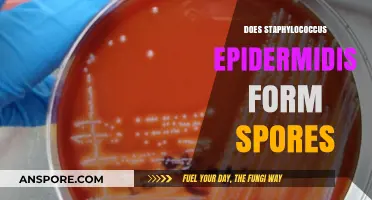
Does Staphylococcus Epidermidis Form Spores? Unraveling the Truth

For gamers and simulation enthusiasts, the compatibility of older games with modern operating systems remains a pressing concern. One such game, *Spore*, a life simulation game developed by Maxis and published by Electronic Arts, has garnered a dedicated fan base since its release in 2008. However, as technology advances, users often wonder whether *Spore* can still run smoothly on older systems like Windows 7 64-bit. This question is particularly relevant given that Windows 7, despite being phased out, is still used by a significant number of individuals. Determining whether *Spore* works on Windows 7 64-bit involves examining the game's system requirements, potential compatibility issues, and possible workarounds to ensure an optimal gaming experience.
| Characteristics | Values |
|---|---|
| Compatibility | Spore is compatible with Windows 7 64-bit. |
| System Requirements | - OS: Windows 7 (64-bit) - CPU: 2.0 GHz Intel Pentium 4 or equivalent - RAM: 512 MB (1 GB recommended) - Graphics: 128 MB Video Card with support for Pixel Shader 2.0 |
| Installation | Requires installation from original game disc or digital download. |
| Performance | Runs smoothly on most 64-bit systems meeting minimum requirements. |
| Known Issues | Some users report minor graphical glitches or crashes on older drivers. |
| Patches/Updates | Latest patches (e.g., 1.05) improve stability on Windows 7 64-bit. |
| DRM | SecuROM DRM is present, which may cause issues on some systems. |
| Community Support | Active community forums and mods available for troubleshooting. |
| Availability | Available on platforms like GOG, Origin, and Steam (check for Windows 7 support). |
| Recommended Fixes | Update graphics drivers, run as administrator, or use compatibility mode if issues arise. |
Explore related products
What You'll Learn

System Requirements for Spore on Windows 7 64-bit
Running *Spore* on a Windows 7 64-bit system is feasible, but compatibility hinges on meeting specific system requirements. The game, originally designed for earlier Windows versions, demands a minimum of a 2.0 GHz processor, 512 MB of RAM, and a 128 MB video card with support for Pixel Shader 2.0. For Windows 7 64-bit, ensure your system exceeds these baseline specs, particularly in RAM and graphics, as the 64-bit architecture allows for better resource utilization. Upgrading to 2 GB of RAM and a 256 MB video card will enhance performance, especially during graphically intensive stages like the Space or Creature phases.
Installation on Windows 7 64-bit requires the game’s disc or a digital download from platforms like Origin or GOG. Users often report success by running the installer in compatibility mode for Windows XP SP3, which mitigates potential driver or software conflicts. After installation, right-click the game’s executable, navigate to Properties > Compatibility, and enable "Run this program as an administrator" to ensure smooth operation. Additionally, updating DirectX to version 9.0c or later is crucial, as *Spore* relies heavily on this framework for rendering and audio.
One common issue on 64-bit systems is the game’s inability to recognize certain graphics cards, particularly older models. If *Spore* fails to launch or crashes, verify that your GPU drivers are up to date. NVIDIA and AMD provide legacy drivers for older cards, which can resolve compatibility issues. Alternatively, disabling vertical sync (VSync) in the game’s settings or using third-party tools like DGVoodoo 2 can improve stability by bypassing outdated rendering methods.
For optimal performance, consider tweaking in-game settings to match your hardware capabilities. Lowering shadow quality, disabling anti-aliasing, and reducing draw distance can significantly boost frame rates on mid-range systems. If you encounter audio glitches, ensure your sound drivers are compatible with Windows 7 64-bit and that the game’s audio settings are configured for your output device. Mods like "Dark Injection" not only enhance visuals but also address many technical limitations, though they require careful installation to avoid conflicts.
In summary, *Spore* can run on Windows 7 64-bit with careful attention to system requirements and compatibility adjustments. By ensuring your hardware meets or exceeds the game’s demands, updating drivers, and applying targeted fixes, you can enjoy this classic title without significant technical hurdles. Patience and a methodical approach will yield the best results, allowing you to explore the game’s evolutionary sandbox seamlessly.
Do Bacteria Contain Spores? Unveiling Microbial Survival Strategies
You may want to see also

Compatibility Issues with Windows 7 64-bit
Spore, the iconic evolutionary simulation game, has left many Windows 7 64-bit users scratching their heads over compatibility. The core issue lies in the game’s SecuROM DRM (Digital Rights Management) software, which often conflicts with 64-bit operating systems. This DRM, designed to prevent piracy, ironically becomes the barrier to legitimate play. When installed, SecuROM can trigger errors like "Application failed to start because its side-by-side configuration is incorrect," leaving players stuck at the launch screen.
To address this, a practical workaround involves disabling SecuROM entirely. This can be done by locating the game’s installation folder, finding the "SpoRE.exe" file, and renaming it to "SpoRE_original.exe." Then, rename the "SpoREAppSupport.exe" file to "SpoRE.exe." This bypasses the DRM check, allowing the game to launch. However, this method may violate the game’s terms of service, so proceed with caution. Alternatively, using compatibility mode (right-click the game executable, select Properties > Compatibility > Run as Windows XP SP3) can sometimes resolve the issue without altering files.
Another common problem is outdated graphics drivers, which can cause Spore to crash or display graphical glitches on Windows 7 64-bit. Ensuring your GPU drivers are up-to-date is crucial. For NVIDIA or AMD users, visit the official website and download the latest drivers compatible with Windows 7. If updates aren’t available, try rolling back to a stable version known to work with the game. Additionally, disabling unnecessary background applications via Task Manager can free up system resources, improving stability.
For those still facing issues, community patches and mods offer a lifeline. The "Spore Revitalization Project" and similar fan-made updates address many compatibility problems, including 64-bit support. These patches often include fixes for SecuROM conflicts and optimize performance for modern systems. However, downloading mods from unverified sources carries risks, so stick to trusted forums like Reddit’s r/spore or official modding communities.
In conclusion, while Spore’s compatibility with Windows 7 64-bit isn’t flawless, solutions exist. From DRM workarounds to driver updates and community patches, players have tools to revive this classic game. Patience and a bit of technical know-how can turn frustration into hours of evolutionary fun.
Do Seed Plants Disperse Through Spores? Unraveling Plant Reproduction Myths
You may want to see also

Installing Spore on 64-bit Windows 7
Spore, the evolutionary simulation game developed by Maxis, has a dedicated fan base that continues to enjoy its unique gameplay. For those running Windows 7 64-bit, the question of compatibility arises. Fortunately, Spore is indeed compatible with this operating system, but installation and performance can vary based on specific configurations and updates. Here’s a detailed guide to ensure a smooth installation process.
Steps for Installation: Begin by ensuring your Windows 7 64-bit system is updated to the latest service pack. Insert the Spore installation disc or locate the downloaded installer file. Run the setup as an administrator to avoid permission issues. Follow the on-screen prompts, selecting the default installation path unless you have a specific reason to change it. If prompted, install DirectX and Visual C++ Redistributables, which are often included in the game’s setup files. Once installed, launch the game to check for initial compatibility.
Cautions and Troubleshooting: Some users report issues with Spore’s SecuROM DRM on 64-bit systems. If the game fails to start, try applying the official Spore 1.05 patch, which addresses many compatibility and DRM-related problems. Disable any antivirus or firewall temporarily during installation, as they may interfere with the process. If the game crashes on launch, update your graphics driver to the latest version compatible with Windows 7 64-bit. For persistent issues, consider running the game in compatibility mode for Windows XP SP3, a workaround that has proven effective for many users.
Optimizing Performance: To enhance gameplay, adjust Spore’s graphics settings to match your system’s capabilities. Lowering resolution and disabling anti-aliasing can improve frame rates on older hardware. If you’re using a modern system, enable higher settings to take advantage of the game’s visual potential. Additionally, allocate sufficient RAM to the game by closing background applications. For a seamless experience, ensure your system meets the recommended requirements: a dual-core processor, 2 GB of RAM, and a DirectX 9.0c-compatible graphics card with 256 MB VRAM.
Community Tips and Takeaways: Online forums and communities offer valuable insights for troubleshooting Spore on Windows 7 64-bit. Users often recommend creating a desktop shortcut and running it as an administrator to bypass launch issues. Others suggest using third-party tools like DGVoodoo to improve graphics rendering on modern systems. While Spore is over a decade old, its compatibility with Windows 7 64-bit remains solid with the right approach. By following these steps and leveraging community knowledge, you can relive or discover the joys of Spore on your 64-bit system.
Can Vinegar Kill Tetanus Spores? Debunking Myths and Facts
You may want to see also
Explore related products

Performance of Spore on Windows 7 64-bit
Spore, the evolutionary simulation game developed by Maxis, has a dedicated fan base that continues to explore its compatibility with modern operating systems. For Windows 7 64-bit users, the game’s performance hinges on several factors, including hardware specifications, driver updates, and software patches. While Spore was originally designed for older systems, its lightweight engine generally runs smoothly on 64-bit architectures, provided the system meets the minimum requirements: a 2.0 GHz CPU, 1 GB of RAM, and a 128 MB graphics card. However, users often report minor graphical glitches or frame rate drops, particularly during the Space Stage, which demands more resources.
To optimize performance, start by ensuring your graphics drivers are up to date. NVIDIA and AMD regularly release updates that improve compatibility with older games. Additionally, running Spore in compatibility mode for Windows XP SP3 can resolve issues related to DirectX 9, which the game relies on. Right-click the game executable, select *Properties*, navigate to the *Compatibility* tab, and apply the settings. This simple tweak often eliminates crashes or freezes during gameplay.
Another critical aspect is managing background processes. Windows 7 64-bit systems can handle multitasking, but Spore benefits from closing resource-intensive applications like web browsers or media players before launching the game. Adjusting the game’s graphics settings within the options menu can also improve performance. Lowering shadow quality, disabling anti-aliasing, and reducing draw distance are effective ways to boost frame rates without significantly impacting visual appeal.
For users encountering persistent issues, community-created patches and mods offer solutions. The *Spore Galactic Adventures* expansion, for instance, includes updates that enhance stability on newer systems. Alternatively, tools like *DXVK* can translate DirectX 9 calls to Vulkan, improving performance on modern hardware. However, these methods require technical know-how and should be approached with caution to avoid corrupting game files.
In conclusion, Spore’s performance on Windows 7 64-bit is generally reliable with minor adjustments. By updating drivers, optimizing settings, and leveraging community resources, players can enjoy the game’s unique experience without significant hurdles. While not flawless, the game’s compatibility demonstrates its enduring appeal and adaptability across generations of technology.
Buying Spores in California: Legalities, Sources, and What You Need to Know
You may want to see also

Fixes for Spore Crashes on Windows 7 64-bit
Spore, the beloved evolutionary simulation game, can indeed run on Windows 7 64-bit, but crashes are a common frustration for players. These issues often stem from compatibility quirks between the game’s aging codebase and modern operating systems. Fortunately, several fixes can stabilize Spore and restore its functionality. Below are targeted solutions to address these crashes, backed by user experiences and technical insights.
Step 1: Update DirectX and Visual C++ Redistributables
Spore relies heavily on DirectX 9 and specific Visual C++ libraries, which may not be fully compatible with Windows 7 64-bit out of the box. Start by downloading the latest DirectX End-User Runtimes from Microsoft’s official website. Pair this with installing the Visual C++ Redistributable Packages for Visual Studio 2005, 2008, and 2010 (both 32-bit and 64-bit versions). These updates patch underlying system dependencies, reducing crashes during gameplay or startup.
Step 2: Run Spore in Compatibility Mode
Windows 7’s compatibility mode can mimic older operating systems, tricking Spore into running smoothly. Right-click the Spore executable, select *Properties*, navigate to the *Compatibility* tab, and set the mode to *Windows XP (Service Pack 3)*. Additionally, enable *Run this program as an administrator* and disable *desktop composition* and *display scaling*. These adjustments resolve issues related to outdated graphics handling and privilege restrictions.
Step 3: Modify Graphics Settings
Spore’s crashes often correlate with graphics driver conflicts or overambitious settings. Lower the in-game graphics quality to *Medium* or *Low* and disable anti-aliasing and bloom effects. If crashes persist, update your GPU drivers to the latest stable version or roll back to a previous release known to work with Spore. For NVIDIA users, forcing the game to use a specific GPU via the NVIDIA Control Panel can also prevent crashes caused by multi-GPU setups.
Caution: Avoid Common Pitfalls
While third-party patches or mods like the "Spore Galactic Adventures Fix" can enhance stability, they may introduce new bugs or compatibility issues. Always back up your game files before applying mods. Similarly, be wary of unofficial downloads claiming to fix Spore crashes, as they may contain malware. Stick to verified sources like Steam or Origin for updates and community-approved fixes.
While Spore’s compatibility with Windows 7 64-bit isn’t flawless, these fixes collectively address the most common crash triggers. By updating system components, tweaking compatibility settings, and optimizing graphics, players can enjoy the game’s creative sandbox without frequent interruptions. Patience and methodical troubleshooting are key to reviving this classic for modern systems.
Ammonia's Power: Can It Effectively Kill Mold Spores?
You may want to see also
Frequently asked questions
Yes, Spore is compatible with Windows 7 64-bit. However, you may need to apply updates or patches to ensure optimal performance.
Some users report minor graphical glitches or crashes, but these can often be resolved by updating the game, installing the latest drivers, or running it in compatibility mode.
You may need to install DirectX 9.0c and ensure your graphics drivers are up to date. Some users also recommend installing the latest version of Microsoft Visual C++ Redistributable.
Yes, all Spore expansions are compatible with Windows 7 64-bit, provided the base game runs smoothly. Ensure all expansions are updated to the latest versions.
Try running the game as an administrator, updating your graphics drivers, or verifying the game files if installed via a platform like Origin. Running the game in compatibility mode for Windows XP or Vista may also help.